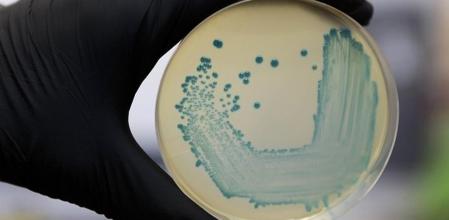
Horizontal

La listeriosis es una enfermedad causada por la bacteria listeria que infecta a las personas a través de alimentos contaminados como ha ocurrido en el brote detectado en Andalucía con más de ochenta afectados tras ingerir carne mechada.
La doctora Belén Padilla, portavoz de la Sociedad Española de Enfermedades Infecciosas y Microbiología Clínica (Seimc) y especialista en el Hospital General Universitario Gregorio Marañón de Madrid, ofrece a EFE las claves para entender esta enfermedad.
Claves para entender la enfermedad
1.- La listeria es una bacteria que se encuentra en el terreno donde entra en contacto con vegetales y animales que la pueden transmitir a las personas a través del consumo de leche y carne.
2.- Incidencia: La incidencia media es de 3 casos por millón de habitantes. “Es una enfermedad que puede ocurrir pero lo que es raro es que haya brotes” como el de Andalucía, apunta la experta.
3.- Brotes: Un brote de listeriosis puede surgir porque el alimento proceda de un animal infectado por la bacteria; porque en la cadena de envasado un alimento puede estar contaminado por otro; o bien porque a la hora de manipularlos se haya podido contaminar. Lo habitual es que la bacteria se extienda en la cadena de procesamiento del alimento.
4.- La listeria aguanta bien el frío, pero no el calor. Hay que cocinar los alimentos por encima de 70 grados y preservarlos a partir de menos de 4 grados para así eliminarla.
5.- Contagio y diagnóstico: No se transmite de persona a persona, solo al ingerir un alimento contaminado. Lo habitual es detectarla en un análisis de sangre del afectado.
6.- Listeriosis inadvertida: Las personas sanas pueden padecer en algún momento esta enfermedad infecciosa que pase inadvertida y con algún síntoma, como una diarrea sin mayor importancia.
7.- Grupos de riesgo: pacientes con enfermedad crónica y con enfermedades inmunodepresoras; mujeres embarazadas con riesgo para el feto o personas mayores de 65 años. Son casos que pueden tener listeriosis sintomáticas y con posibles repercusiones graves.
Puede presentar síntomas no graves, como una gastroenteritis con algo de fiebre, o llegar a síntomas graves como meningitis en fetos y bebés
8.- Curso de la enfermedad: puede ser prácticamente asintomática, presentar síntomas no graves, como una gastroenteritis con algo de fiebre, o llegar a síntomas graves como meningitis en fetos y bebés. En casos muy graves puede haber secuelas neurológicas.
9.- Tratamiento: Con antibióticos vía oral. La listeria no se ha mostrado resistente a estos fármacos y no tiene por qué permanecer latente en el organismo.
10.- Duración: La infección y su tratamiento puede durar de cinco a siete días en casos leves, mientras que en situaciones graves el tratamiento se prolonga a partir de dos semanas.
Inicio en Andalucía
Por el momento, el número de enfermos hospitalizadas por el brote de listeriosis detectado en Andalucía ha aumentado hasta los 56, aunque el Gobierno autonómico cree que se pueden producir más casos en los próximos días, pues la sintomatología de esta afección puede tardar más de cuatro semanas en aparecer.
Salud ha confirmado que hasta la fecha se han comprobado 80 intoxicados, 66 en la provincia de Sevilla, principal afectada por este brote, cinco en Huelva, y tres en Málaga, Cádiz y Granada.
El subdirector de Protección de Salud de la Junta, Jesús Peinado, ha destacado que la empresa sevillana Magrudis, fabricante de la carne mechada “La Mechá”, identificada como el origen de este brote, paralizó su producción el 15 de agosto, nada más decretarse la alerta sanitaria, e informó del problema sanitario a todos sus clientes para que retirasen este producto de la venta.
“La ingente mayoría de la carne se ha distribuido en Andalucía”, ha señalado Peinado, quien ha informado de que en el listado “de más de doscientos folios” de clientes a los que se enviaron lotes de “La Mechá” figuran una empresa extremeña, que recibió “una muestra comercial”; una central de compras con sede en Girona, pero que comercializa casi todos sus productos en Andalucía y una tienda de Madrid, cuya identidad no ha desvelado.
El brote que crece
Unas “cantidades mínimas” de la carne afectada por la bacteria listeria moncytogenes llegaron también a Castilla la Mancha y Tenerife, además de a Andalucía -donde se distribuyó la mayoría- y a las comunidades de Madrid y Extremadura, comunidad esta última en la que ya se ha confirmado un caso.
Así lo ha confirmado la ministra de Sanidad, Consumo y Bienestar Social en funciones, María Luisa Carcedo, en declaraciones a la Cadena Ser, donde ha precisado que, además de los 80 casos de intoxicación en Andalucía y las dos sospechas de aborto, se ha confirmado un caso de listeriosis en Extremadura y hay otros cuatro en estudio en esta comunidad y la posibilidad de otro en Madrid.